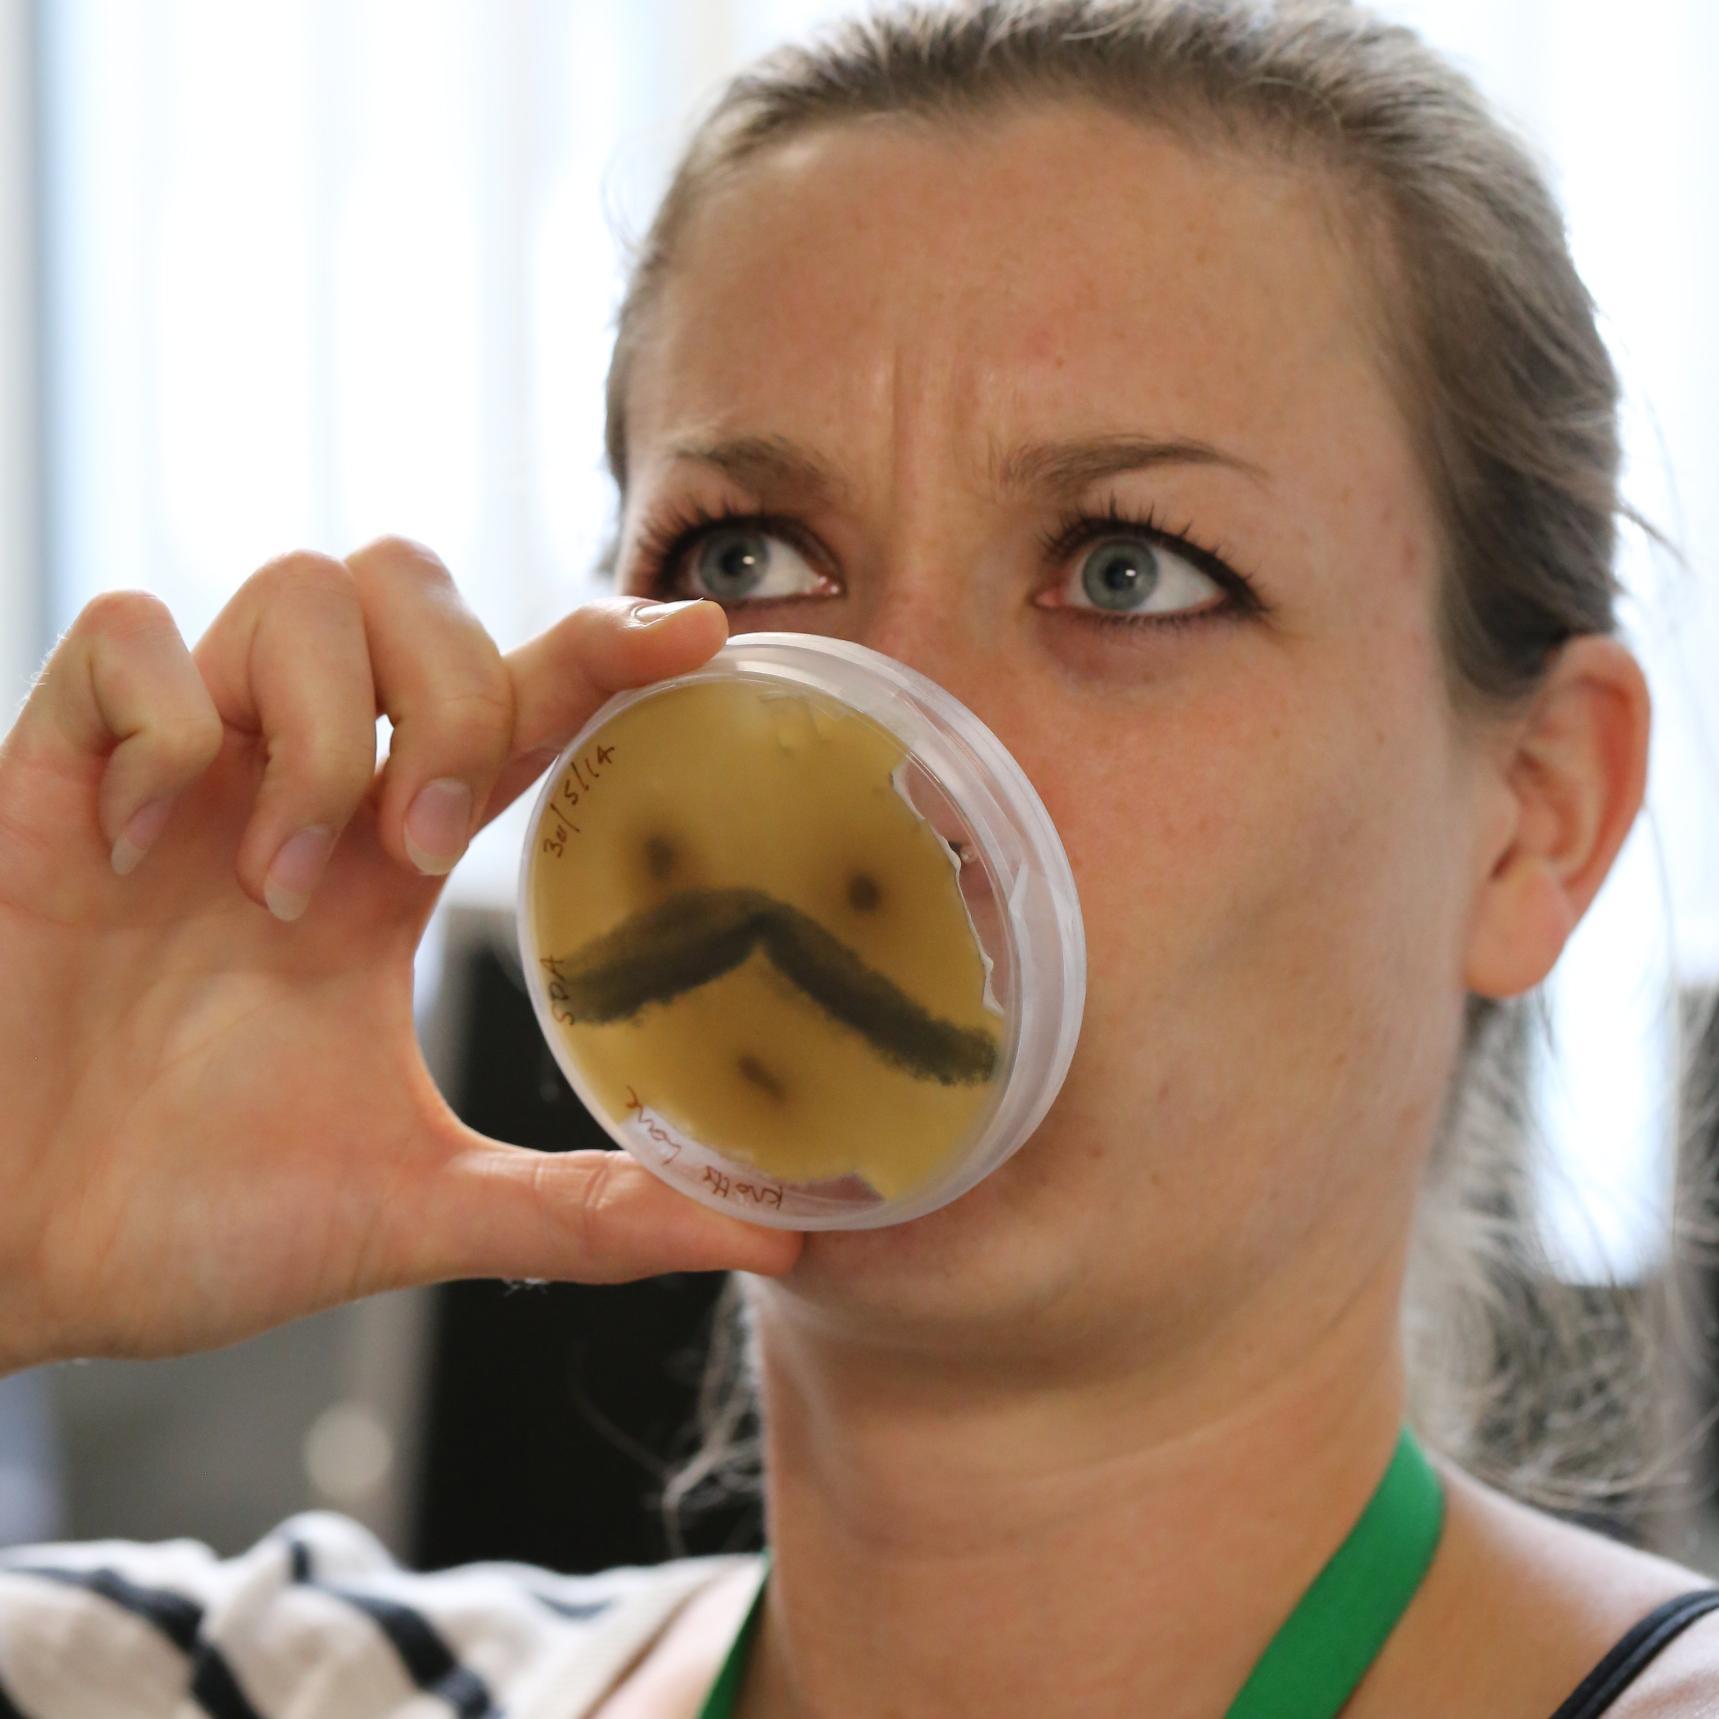

MacColl Stickleback Lab @MacColl_Lab
Andrew MacColl's stickleback lab based @UoNLifeSci studying ecology, evolution, genetics and behaviour in the wonderful three-spined stickleback! 🐟🐟 ecology.nottingham.ac.uk/AndrewMacColl/… Nottingham, England Joined May 2018-
Tweets54
-
Followers159
-
Following126
-
Likes50
New MacColl lab paper "On the origins of phenotypic parallelism in benthic and limnetic stickleback" in Molecular Biology & Evolution @MolBioEvol doi.org/10.1093/molbev…
Thanks very much to @MeropsField for their many contributions to the UoN Biodiversity field course in the Cevennes: very warm welcome, great food and wonderful biodiversity.
JOB VACANCY! We have a new aquarium research technician role available in the MacColl lab. Permanent, full time, University of Nottingham. Click the link for more info jobs.nottingham.ac.uk/vacancy.aspx?r…
📣 We have a funded @ENVISIONDTP PhD open for applications 📣 on the effect of environ metals on AMR in the stickleback microbiome🦠🐟 Supervisory team includes myself, @MacColl_Lab, & @hahartikainen from @UoNLifeSci w/ input from @Napaaqtuk More info: tinyurl.com/5n8vchpf
Did the benthic and limnetic stickleback in BC have a single origin? Manuscript now on @biorxivpreprint biorxiv.org/content/10.110…
New MacColl lab paper "Courtship behaviour, nesting microhabitat and assortative mating in sympatric stickleback species pairs" in Ecology and Evolution onlinelibrary.wiley.com/doi/epdf/10.10…
“‘Intercontinental genomic parallelism in multiple three-spined stickleback adaptive radiations” in Nature Ecology and Evolution nature.com/articles/s4155…
Parallelism provides evidence of natural selection, but studies with pre-selected taxon pairs are likely biased. We demonstrate parallelism in an intercontinental study of #stickleback, without bias. Congratulations Isabel Magalhaes, @jimwhiting_sci , @DanDagostino_ et al.
New #PhD opportunity in the MacColl Lab Functional consequences of #mitochondria variation in #stickleback Fun, fishy fieldwork and physiology envision-dtp.org/projects/ findaphd.com/phds/program/e… @lisalabbook @Making_Ripples @sos_bangor_uni @UoNLifeSci #Evolution #Ecology #Genetics
Nice work Stu! This is an important result for #ecoimmunology
Nice work Stu! This is an important result for #ecoimmunology
A new paper by Jim Whiting shows for the first time that summer day length results in changes to immune function in fish and a reduced ability to resist a parasitic infection, probably as a consequence of inducing breeding condition royalsocietypublishing.org/doi/10.1098/rs…
The MacColl lab has a new manuscript out, describing genomic parallelism across multiple adaptive radiations of stickleback in Alaska, British Columbia, Scotland and Iceland: biorxiv.org/content/10.110…
Interdisciplinary investigation into sympartric species-pairs... What do they look like? How reproductively isolated are they? How did they form? And why here and now? #science #biology #ecology #speciation #evolution #Genomics #stickleback
Interdisciplinary investigation into sympartric species-pairs... What do they look like? How reproductively isolated are they? How did they form? And why here and now? #science #biology #ecology #speciation #evolution #Genomics #stickleback
New exciting @UoNLifeSci research: Immune state is diet dependent in wild house mice, Mus musculus domesticus besjournals.onlinelibrary.wiley.com/doi/10.1111/13…
Our 'Virgin Mary' paper is out. Read it to find out about the #stickleback immaculate conception, pregnancy and virgin birth! rdcu.be/bnEWz @UoNLifeSci @UoNScience @UoNPressOffice
Our 'Virgin Mary' paper is out. Read it to find out about the #stickleback immaculate conception, pregnancy and virgin birth! rdcu.be/bnEWz @UoNLifeSci @UoNScience @UoNPressOffice
We've an exciting new paper out in @EvolLetters showing that Stickleback fish adapt predictably to acidic conditions #evolution #genetics #Genomics
We've an exciting new paper out in @EvolLetters showing that Stickleback fish adapt predictably to acidic conditions #evolution #genetics #Genomics
Correction the closing date is this Sunday (27th). Applications will be accepted here: envision-dtp.org/2018/holey-hyp…
Correction the closing date is this Sunday (27th). Applications will be accepted here: envision-dtp.org/2018/holey-hyp…
Last chance to apply, fully funded #PhD combining #maths with #evolutionarybiology. A rare and fantastic opportunity for an interdisciplinary PhD. The closing date for applications is 25th Jan and not many applications have been received yet - don't miss out. #PhDchat #PhDlife
Last chance to apply, fully funded #PhD combining #maths with #evolutionarybiology. A rare and fantastic opportunity for an interdisciplinary PhD. The closing date for applications is 25th Jan and not many applications have been received yet - don't miss out. #PhDchat #PhDlife
New paper with @MacColl_Lab input just out in @ScienceMagazine showing how rapid mutatation rates can facilitate repeated adaptation to new environments. science.sciencemag.org/content/363/64… #Stickleback #Genetics #Evolution

Mark Ravinet @Mark_Ravinet
2K Followers 680 Following Ramen addicted evolutionary biologist working on genomics, speciation, sticklebacks and sparrows. Views my own. Now on Mastodon too: @[email protected]
Tristan A F Long 🪰... @thelonglab
3K Followers 5K Following Associate Professor @Laurier @LaurierBiology Evolutionary Genetics & Behavioural Ecology #DrosLife #ScienceDoughnuts #JournalKlatch ORCID: 0000-0002-8708-2728
Natalie Pilakouta @NPilakouta
2K Followers 799 Following Evolutionary biologist & behavioural ecologist | Fishes & insects 🐟🐞 | Lecturer @UnivofStAndrews | Editor @AnimalEcology @FunEcology @JEvBio @J_Therm_Biol
UoN Life Sciences @UoNLifeSci
3K Followers 546 Following The School of Life Sciences covers a wide spectrum of biological and medical sciences in both teaching and research, part of @UoNFacultyMHS
James McInerney @jomcinerney
12K Followers 9K Following Chair in Evolutionary Biology and Head of Department. Open Science Advocate. Emigrant. #Python Machine learning. #Pangenomes 🇮🇪 #firstgen He/Him
Kieran Samuk @ksamuk
2K Followers 2K Following Assistant Professor in the EEOB Department @UCRiverside. Studying evolution and recombination using genomics. 🇨🇦🔬🖥️. Also: @ksamuk.bsky.social
Erik Svensson @EvolOdonata
8K Followers 5K Following Evolutionary biologist, photographer & professor. @[email protected] https://t.co/HoEI1f2x7A https://t.co/FLWu84vyLh
Dr. Kiyoko Gotanda @photopidge
2K Followers 2K Following Former ballet dancer. Ecology/Evolution/Behaviour. Assistant Professor @BrockUniv @BrockUFMS Tweets my own. she/her. Photos: https://t.co/w68ISM5cBn Wear a mask
Rabi Sankar Pal @Ra_Sa_Pa_
134 Followers 514 Following PhD candidate @IISER_BERHAMPUR curious about reproductive evolution | Behavioural/Evolutionary/Wildlife ecology | @presiuniv, @wii_india alumnus | ⚽ & Sculpting
Theesheath @Theesheath1Js2
9 Followers 632 Following
Pete Liptrot @Hyosube
766 Followers 1K Following
Raziyeh Abdilzadeh @Razii1026
510 Followers 2K Following Evolutionary genomics researcher, adaptation, coevolution, extremophiles, polyploidy, and population genetics.
Alexander Schlatmann @AASchlatmann
109 Followers 114 Following PhD student @univgroningen in the @sticklelab | You can now also find me on BlueSky: https://t.co/gknB7eSAdQ
Tawfiqur Rahman @Tawfiqur91
70 Followers 219 Following Doctoral researcher at the University of Helsinki. #Behavioural Ecology #Climate change #Species response. Candolin lab.-All tweets are mine-
Heather Alexander @heather_j_alex
69 Followers 167 Following West coast islander, kiteboarder, nature lover, traveller. Chasing the wind. Full circle to freshwater fish research.
Leah Strople @leah_strople
366 Followers 1K Following
Gyapong Francis @F_Gyapong
237 Followers 761 Following #PhD #candidate @UniofNottingham #MPhil @WACCBIP_UG #Member @MicrobioSoc @ASMicrobiology #SkinMicrobiome #Stickleback #Bioinformatics #Bacteria
Dmitry Lajus @DmitryLajus
0 Followers 6 Following
Mehrab Chowdhury @MehrabChowdhu10
4 Followers 46 Following
Harry Harvey @DrHJHarvey
117 Followers 189 Following Microbiology PhD, post-doc @UniofNottingham examining food spoilage and prevention in collaboration with @SuntoryBF_GBI
Jack Harper @jack_harper_
111 Followers 218 Following University of Nottingham PhD student working on rapid evolution in invasive house sparrows
Emma Curran @EvCurran
419 Followers 560 Following Postdoc in Evolutionary Genomics @UoNLifeSci. Likes playing outside and drawing. she/her.
Merops Field Studies @MeropsField
136 Followers 282 Following Mediterranean Ecology Research Observatory for Practical Skills Created by Dr Sophie Mowles and Dr Fabrizio Manco
Jolle Jolles @JolleWJolles
2K Followers 1K Following Behavioural Biologist | Senior Research Scientist at @ceabcsic | the JollesLab | We study how animals live and move together and cope with environmental change
labecoevobuap @labecoevobuap
71 Followers 453 Following Laboratorio de Ecología Evolutiva de la BUAP coordinado por la Dra. Palestina Guevara Fiore, de la Facultad de Ciencias Biológicas.
Sann44 @Sann442
62 Followers 99 Following PhD Student- Evolutionary genomics- three-spined stickleback🐟- Laval University
Amelie Cant @ameliecant
65 Followers 252 Following Phd in ecotoxicology UMR-I 02 SEBIO (12/2022) Ineris Reims Aquatic #ecotoxicology #biomarkers #genotoxicity #stickleback #biomonitoring
Bjarni Jónsson @Bjarni_Jonsson
338 Followers 1K Following Chair Foreign Affairs Committee, Chair Icelandic delegation Council of Europe Parliamentary Assembly, Member of Parliament Althingi.
JC Cubillos @JC_Cubil... @JC_Cubillos21
165 Followers 733 Following PhD researcher at @UniOldenburg @Dynacomproject working with small🐟 and big 🦈. Evolutionary Genomics | Speciation #molevol 🇨🇴 🇩🇪
Jason Keagy @Jason_Keagy
245 Followers 442 Following Animal behavior, cognition, and genomics; dad; biker (of the pedal variety); aspiring gardener; likes finding and watching critters; tweets are my own
Halszka Glowacka @HalszkaG
373 Followers 257 Following Assistant Professor UA COMP. evolutionary anthropology // biomechanics // life history evolution // growth and development // dental ecology // anatomy
GG Scholars Program -... @NCStateGGAGrad
435 Followers 852 Following The GG Scholars program is building future scientists in cutting-edge research in the field of genetics. https://t.co/OHrVKtuwKb
Victoria Pritchard @Fishissitude
941 Followers 959 Following Conservation genetics. Evolutionary genomics. A chequered history in Finland, New Mexico, California & Dorset. No to justified text!
Dan Jeffries @Dan_Jeffries
378 Followers 607 Following Evolutionary biologist @UniBern, Suisse - Genome evolution; sex chromosomes; sex determination; adaptation with large scale genomics. Co-founder of @TreeOfSex
Seth Shirazi @sethshirazi
156 Followers 434 Following EEOB PhD Candidate at @UCRiverside in the @HighamLab. Evolutionary biomechanics. @UOregon alumn
İrem Şahan @remahan56992232
0 Followers 56 Following
Clare MT @ClareTempley
372 Followers 465 Following Student vet nurse. MSci Zoology. Former lab tech. Animal artist. Mental health & sustainability advocate. Views my own
Katarina Tresova Pipo... @katatrepip
147 Followers 427 Following PhD researcher at @imperialcollege with @EETrustUK studying same-sex sexual behaviour in primates
louise chavarie @louisechavarie
2K Followers 2K Following 🇨🇦 Associate professor at the Norwegian University of Life Sciences, salmonids, evolutionary ecology, aquatic ecology, fisheries. @[email protected]
Magdalena Bohutínsk�... @MajdaHolcova
852 Followers 576 Following Evolutionary genomics. ❤️s repeated adaptation Follow me at https://t.co/wL0uZnrTYB @MSCActions fellow at IEE @unibern🇨🇭and @science_charles 🇨🇿
Roz Bown @rozbown
917 Followers 4K Following 🐢 @marinevertsMSc 20/21 🦈 🎓 BSc Marine Bio 🌎 Movement ecology 🐟 Fisheries 🏝️ MPAs 🐠 Policy She/Her
Shannon @Shannon07238189
2 Followers 91 Following
Max Reynolds @maxj_reynolds
229 Followers 660 Following Master’s student at UW-Madison | interested in invasive species, fisheries, and invertebrates | he/him | 🏳️🌈
Subrata Gayen @SubuGoku
211 Followers 2K Following
Danai Kontou @KontouD
651 Followers 2K Following Postdoc Research Fellow in Aquatic Invasions @ScienceLeeds 💧🐠 👽 | #Ecology #Conservation #Genetics 🧬🌎 | Nature enthusiast 💚 | 🇪🇺🇬🇷🇨🇦🇬🇧
Bahar Bagheri, PhD �... @baharbagheri_SA
341 Followers 2K Following Postdoc | Microbiologist | Microbe-Microbe Interactions | NGS | GC-FID | Sci Comm on the side | Fan of gardening, coaching students& teamwork.
Matthew Jones @drmattjones
1K Followers 2K Following Professor @UoNGeography; thinking forward by looking backward with @UoNFutureFood; contributor @TheBeestonian; tweeting for myself.
blake matthews @ebmatthews
1K Followers 2K Following Canadian evolutionary ecologist studying aquatic ecosystems (mostly in Greenland and Switzerland), focusing on stickleback, isopods, and zooplankton (copepods).
Mark Ravinet @Mark_Ravinet
2K Followers 680 Following Ramen addicted evolutionary biologist working on genomics, speciation, sticklebacks and sparrows. Views my own. Now on Mastodon too: @[email protected]
Andrew Hendry @EcoEvoEvoEco
6K Followers 93 Following Professor of Eco-Evolutionary Dynamics @McGillU https://t.co/aWicMui9tg website: https://t.co/HB6R4J5iin https://t.co/hrBI7Ctg1k
Natalie Pilakouta @NPilakouta
2K Followers 799 Following Evolutionary biologist & behavioural ecologist | Fishes & insects 🐟🐞 | Lecturer @UnivofStAndrews | Editor @AnimalEcology @FunEcology @JEvBio @J_Therm_Biol
Joel McGlothlin @joelmcglothlin
8K Followers 7K Following Evolutionary biologist. Associate Professor at Virginia Tech.
UoN Life Sciences @UoNLifeSci
3K Followers 546 Following The School of Life Sciences covers a wide spectrum of biological and medical sciences in both teaching and research, part of @UoNFacultyMHS
James McInerney @jomcinerney
12K Followers 9K Following Chair in Evolutionary Biology and Head of Department. Open Science Advocate. Emigrant. #Python Machine learning. #Pangenomes 🇮🇪 #firstgen He/Him
Harry Harvey @DrHJHarvey
117 Followers 189 Following Microbiology PhD, post-doc @UniofNottingham examining food spoilage and prevention in collaboration with @SuntoryBF_GBI
Jack Harper @jack_harper_
111 Followers 218 Following University of Nottingham PhD student working on rapid evolution in invasive house sparrows
Emma Curran @EvCurran
419 Followers 560 Following Postdoc in Evolutionary Genomics @UoNLifeSci. Likes playing outside and drawing. she/her.
Britta Meyer🐦🐟�... @MeyerBritta
644 Followers 1K Following Evolutionary Biologist, (immuno)genomics @evotobi at @UniHH, previous ageing, epigenetics @GenMig, @CommonTerns, @MarineEvolEcol 🐟 and 🐦, @evomics, 🍫☕️
Magdalena Bohutínsk�... @MajdaHolcova
852 Followers 576 Following Evolutionary genomics. ❤️s repeated adaptation Follow me at https://t.co/wL0uZnrTYB @MSCActions fellow at IEE @unibern🇨🇭and @science_charles 🇨🇿
David Marques @David_A_Marques
911 Followers 702 Following Evolutionary biologist, genomics of speciation & adaptation, NHM Basel, #TeamBird and #TeamFish. Views my own. He/him. Mastodon: @[email protected]
Asano Ishikawa @AsanoIshikawa
1K Followers 755 Following
Sophie Evison @Sop_Evo
354 Followers 367 Following Evolutionary Biologist: social insect biology, host-parasite interactions, ecological immunology. Views generally influenced by others.
marta @BarluengaMarta
422 Followers 337 Following Evolutionary Biologist. Working at Museo Nacional Ciencias Naturales-CSIC.
Joost Raeymaekers @JoostRaeymkrs
852 Followers 851 Following Full Professor in evolutionary ecology & population genetics @norduniversitet
blake matthews @ebmatthews
1K Followers 2K Following Canadian evolutionary ecologist studying aquatic ecosystems (mostly in Greenland and Switzerland), focusing on stickleback, isopods, and zooplankton (copepods).
Fiona J. Whelan @whelanfj
2K Followers 1K Following Senior Lecturer & 2023 Lister Prize Fellow at U of Manchester. Bioinf, microbes, running, cycling, pub chats. she/her 🇨🇦. bsky: whelanfj.
Ulrika Candolin @ulrikacandolin
998 Followers 187 Following Behavioural ecologist at Helsinki University. Focussing on responses to environmental change.
Ecology Letters @Ecology_Letters
13K Followers 7 Following
Science Magazine @ScienceMagazine
4.5M Followers 460 Following Cutting-edge research, news, commentary, and visuals from the Science family of journals. Follow @NewsfromScience for stories from our News team.
Tim @biotim
879 Followers 5K Following Biology and Evolution. Data science and Bioinformatics. Cool animal photos.
Andrew Wolfenden @A__Wolfenden
51 Followers 31 Following Ecologist. Fish lover. Pessimist. Research fellow at the University of Nottingham.
Susana Wadgymar 🌿�... @SMWadgymar
3K Followers 1K Following Evolutionary ecologist, Botanist, Davidson College, she/her **No longer active here, content deleted, my username on other sites: smwadgymar
Mark Fellowes @BaobabJ
2K Followers 701 Following Pro-Vice-Chancellor & Professor of Zoology @RoyalHolloway; likes nature, wildlife, urban ecology & sustainability, sometimes HE issues; views own not employer's
UoN Sustainability @UoNSustain
3K Followers 967 Following Here to make the University of Nottingham Greener - can you help? Facebook & Instagram - UoN Sustainability [email protected]
Highfield squirrel @UPsquirrel
433 Followers 201 Following I'm a squirrel living by the lake next to University Park at the University of Nuttingham. I train humans to give me treats and I'm a black belt in dog evasion.
Johan Eklöf @Dr_Oakleaf
1K Followers 722 Following Professor @Stockholm_Uni, partner & father of 2. Biodiversity, Biotic interactions, Resilience, Eco services, Climate change, Guitars. [email protected]
Rachel Stubbington @rstubbington
1K Followers 77 Following Teacher, learner, and a fan of temporary streams and their aquatic–terrestrial biodiversity | Professor of River Ecology @NTUSciTech | Fellow @freshwaterbio
Introgression Papers @_introgression
2K Followers 0 Following Bot aggregating papers and pre-prints on (mostly interspecific) gene flow. Curated by @AnthonyGeneva
Uni of Nottingham Pre... @UoNPressOffice
8K Followers 2K Following Follow us for the latest news, research stories, events & expert commentary from the @UniofNottingham Press Office. Contact us at [email protected]
Home Office @ukhomeoffice
1.1M Followers 513 Following We are the lead UK government department for immigration & passports, crime & policing, homeland security and protecting vulnerable people.
Iain Hill @IainHill15
4 Followers 18 Following
Prof Mary J. O'Connel... @Evol_Molly
2K Followers 2K Following Irish Evolutionary biologist. Interested in comparative genomics, evolution and phenotypic change. Academic at Uni of Nottingham, UK
Victoria Pritchard @Fishissitude
941 Followers 959 Following Conservation genetics. Evolutionary genomics. A chequered history in Finland, New Mexico, California & Dorset. No to justified text!
Clément Rougeux @clem_rougeux
352 Followers 394 Following Interested by Evolution | Convergence | Adaptation | Speciation - Being outdoor Postdoc, Yeaman Lab @ UofCalgary
Tyler Harvey-Cowlisha... @TylerCowlishaw
136 Followers 327 Following Lab technician in life sciences Founder of the Science Apprenticeship Forum Winner of RSB Apprentice of the Year 2022
Ecological Genomics @ecogenksu
487 Followers 1K Following
Fredrik Jutfelt @jutf... @FredrikJutfelt
7K Followers 3K Following Professor @goteborgsuni (Sweden). Animal physiology, climate change, scientific misconduct. Find me here https://t.co/Cy82yIIE3W
Joshka Kaufmann @JoshkaKaufmann
502 Followers 671 Following Evolutionary ecologist at the Marine Institute, Newport. SFI-IRC Pathway PI. Father of 2. @FishEcoEvo @MarineInst @[email protected] (he/his)
CalMac Service Info @CalMac_Updates
48K Followers 244 Following Official CalMac service account. Your first stop for customer service, updates and information. Available from 08:00 to 20:00.
CalMac Ferries @CalMacFerries
39K Followers 1K Following The official account of Caledonian MacBrayne. Serving the Clyde and Hebridean Islands on Scotland's west coast. For service info please follow @CalMac_Updates
Visit Outer Hebrides @OuterHebs
29K Followers 365 Following Warm your soul in Scotland's Atlantic Islands. Official Tourism Organisation for the Outer Hebrides. https://t.co/cjMLRXP6bm…
North Uist @north_uist
4K Followers 190 Following North Uist is an island in the remote Outer Hebrides of Scotland. Together with South Uist, Benbecula and Berneray, they make up a magical island paradise.
Nottinghamshire Wildl... @Nottswildlife
15K Followers 1K Following We want to create a #WilderFuture for the people and wildlife of Nottinghamshire! 💚🐾
Laura Deeprose @LauraDeeprose
147 Followers 200 Following
Sean Hoban @seanmhoban
3K Followers 2K Following Conservation biologist & tree geneticist. How will species respond to climate? How can we optimize conservation? How to monitor biodiversity and inform policy?
Harriet Johnson @harrietfjohnson
95 Followers 162 Following Sequencing scientist, mainly RNA Seq, general next-gen sequencing razzmatazz, dabble in environmental DNA metabarcoding... still a soft spot for snails
Fish-Sci @FishSci
616 Followers 124 Following Twitter feed of the Fish-Sci mailing list: summary of posts and links of interest to list-members (fish biologists, scientists etc). Managed by @chris_harrod
Sarah Kim Pearson @sarahkimpearson
499 Followers 956 Following Conservation. Community. Doing and applying science. Molecular Ecology PhD. Fresh air, a good curry, the arts & the natural world give me joy!
Colin Bean @ProfColinBean
3K Followers 1K Following Conservation biologist who, like a dead fish, just goes with the flow. All views expressed are my own and RTs ≠ endorsements. Leantóir CelticFC 🍀